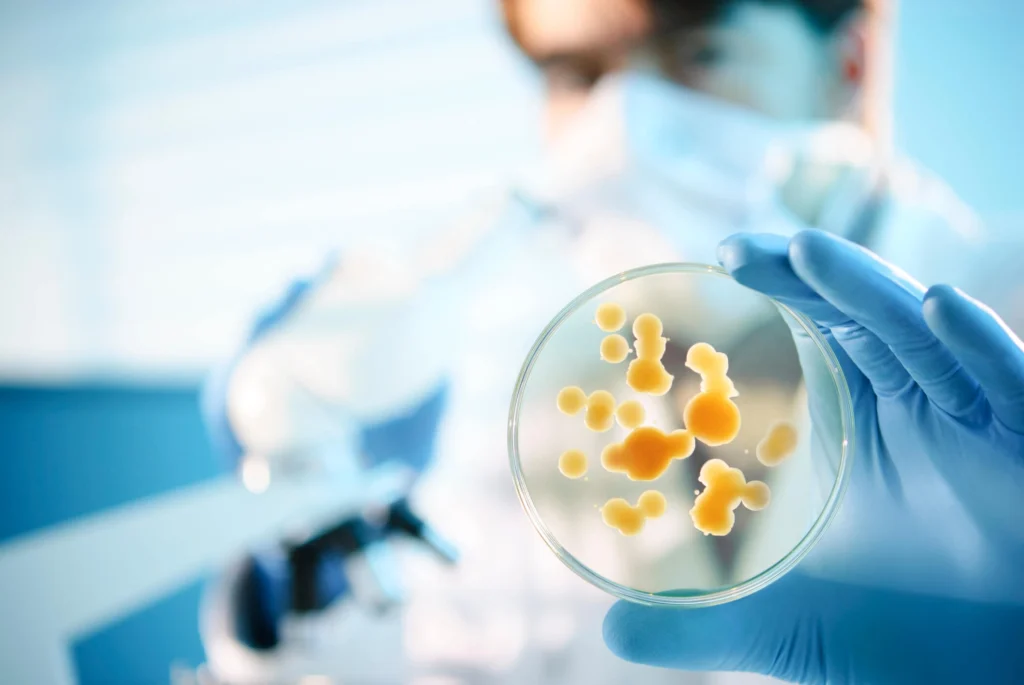
Antibiotic Classes

Antibiotics remain one of the most essential tools in modern medicine. From treating simple bacterial infections to managing life-threatening diseases, they play a critical role in healthcare. However, understanding the different antibiotic classes and how they work is vital for healthcare professionals, especially nurses who administer and monitor these medications daily.
If someone asked you to explain an antibiotic classes list, differentiate broad spectrum vs narrow spectrum antibiotics, or describe the mechanism of action antibiotics, would you feel confident in your answer? This article explores the major antibiotic categories, how they function, and why continuing education is essential for staying updated in clinical practice.
Content
Understanding Antibiotic Classes
Antibiotics are categorized into groups based on their chemical structure, mechanism of action, and the types of bacteria they target. This classification helps healthcare professionals choose the most appropriate drug for a specific infection.
A simplified antibiotic classes list commonly includes:
- Beta-lactam antibiotics
- Macrolides
- Tetracyclines
- Quinolones (Fluoroquinolones)
- Aminoglycosides
- Sulfonamides
- Glycopeptides
Each class works differently to stop bacterial growth or kill bacteria entirely.
Understanding these distinctions helps clinicians select effective treatments while minimizing the risk of complications and drug resistance.
Mechanism of Action: How Antibiotics Work
The mechanism of action antibiotics refers to how a drug interferes with bacterial survival. Most antibiotics target essential bacterial processes.
Common mechanisms include:
1. Inhibiting Cell Wall Synthesis
Drugs in this category weaken the bacterial cell wall, causing the cell to burst.
The most well-known examples are beta-lactam antibiotics, which include:
- Penicillins
- Cephalosporins
- Carbapenems
These medications are widely used because they are effective and relatively safe.
2. Blocking Protein Synthesis
Some antibiotics prevent bacteria from producing essential proteins.
Examples include:
- Macrolides tetracyclines quinolones (partially overlapping groups in education discussions)
- Aminoglycosides
Macrolides and tetracyclines specifically bind to bacterial ribosomes, halting protein production.
3. Disrupting DNA Replication
Fluoroquinolones interfere with bacterial DNA replication, preventing bacteria from multiplying.
4. Interfering with Metabolic Pathways
Some antibiotics block metabolic processes necessary for bacterial survival.
Understanding these mechanisms helps clinicians predict drug effectiveness and possible side effects.
Broad Spectrum vs Narrow Spectrum Antibiotics
Another important concept in antimicrobial therapy is broad spectrum vs narrow spectrum antibiotics.
Broad Spectrum Antibiotics
These drugs act against many types of bacteria, including both Gram-positive and Gram-negative organisms.
Examples include:
- Tetracyclines
- Some fluoroquinolones
- Certain cephalosporins
Broad spectrum antibiotics are useful when the exact pathogen is unknown. However, overuse may increase the risk of antibiotic resistance mechanisms.
Narrow Spectrum Antibiotics
These medications target specific bacteria.
Advantages include:
- Reduced disruption of normal microbiota
- Lower risk of resistance development
- More precise therapy
Clinicians typically prefer narrow-spectrum drugs once the infectious organism has been identified.
The Growing Threat of Antibiotic Resistance
One of the most significant challenges in healthcare today is antibiotic resistance.
Bacteria evolve through several antibiotic resistance mechanisms, such as:
- Producing enzymes that destroy antibiotics
- Altering drug targets inside the cell
- Pumping antibiotics out of the bacterial cell
- Preventing drug entry into the cell
These adaptations make previously effective medications useless.
Improper prescribing, incomplete treatment courses, and overuse of broad-spectrum antibiotics accelerate this problem.
Healthcare professionals must remain informed and follow antimicrobial stewardship guidelines to combat resistance.
Using an Antibiotic Spectrum Chart
Many clinicians rely on an antibiotic spectrum chart when selecting therapy.
These charts display:
- Which bacteria each antibiotic targets
- Whether the drug is broad or narrow spectrum
- Clinical indications and limitations
For nurses and medical students, reviewing antibiotic spectrum charts improves decision-making and medication safety.
They are especially helpful in hospital settings where rapid treatment decisions must be made.
Why Continuing Education Matters for Nurses
Antibiotic therapy evolves constantly due to emerging resistance patterns and new drug developments. Nurses must stay updated through continuing education (CE).
Continuing education helps nurses:
- Understand updated treatment guidelines
- Recognize adverse drug reactions
- Monitor patients receiving antibiotics
- Prevent medication errors
Many nurses complete nursing CEUs online, which provide convenient ways to maintain licensure while improving clinical knowledge.
Platforms such as Fast CE For Less offer courses covering pharmacology, infection control, and antimicrobial therapy. These educational programs can help nurses strengthen their understanding of complex topics like antibiotic classes and resistance mechanisms.
Continuing education is particularly important for nurses involved in:
- ICU care
- Infectious disease units
- Emergency departments
- Long-term care facilities
In these settings, antibiotic administration and monitoring are daily responsibilities.
Recognizing Antibiotic Side Effects
Antibiotics are life-saving medications, but they can also cause complications.
Common adverse reactions to medication include:
- Allergic reactions
- Gastrointestinal upset
- Drug interactions
- Liver or kidney toxicity
Some antibiotics may also lead to secondary infections such as Clostridioides difficile.
Nurses play a crucial role in identifying early warning signs and reporting them promptly.
Monitoring laboratory values is also important. For example, some antibiotics can affect blood counts, potentially contributing to conditions such as leukopenia or low white blood cell count.
Building Confidence in Antibiotic Knowledge
Understanding antibiotic therapy is more than memorizing a drug list. Healthcare professionals must understand:
- Drug classifications
- Mechanisms of action
- Resistance patterns
- Appropriate clinical use
Reviewing a clear antibiotic classes list, studying broad spectrum vs narrow spectrum antibiotics, and understanding antibiotic resistance mechanisms are essential components of clinical competence.
For nurses, continuing education ensures these skills remain current and evidence-based.
Final Thoughts
Antibiotics revolutionized medicine, but their effectiveness depends on proper use. Whether you’re a nursing student, practicing RN, or healthcare professional, mastering the fundamentals of antibiotic therapy is crucial.
Knowing how beta-lactam antibiotics, macrolides, tetracyclines, and quinolones work—and when to use them—helps improve patient outcomes and reduce the spread of resistance.
Continuing education, clinical practice, and regular review of antibiotic spectrum charts can strengthen your knowledge and confidence.
So the question remains: Are you truly confident in your understanding of antibiotic classes? Continuous learning may be the key to keeping both your knowledge—and your patients—safe.

Emma’s love for romance novels knows no bounds. She believes in the magic of love stories and can’t wait to share her favorite heartwarming reads with you.






